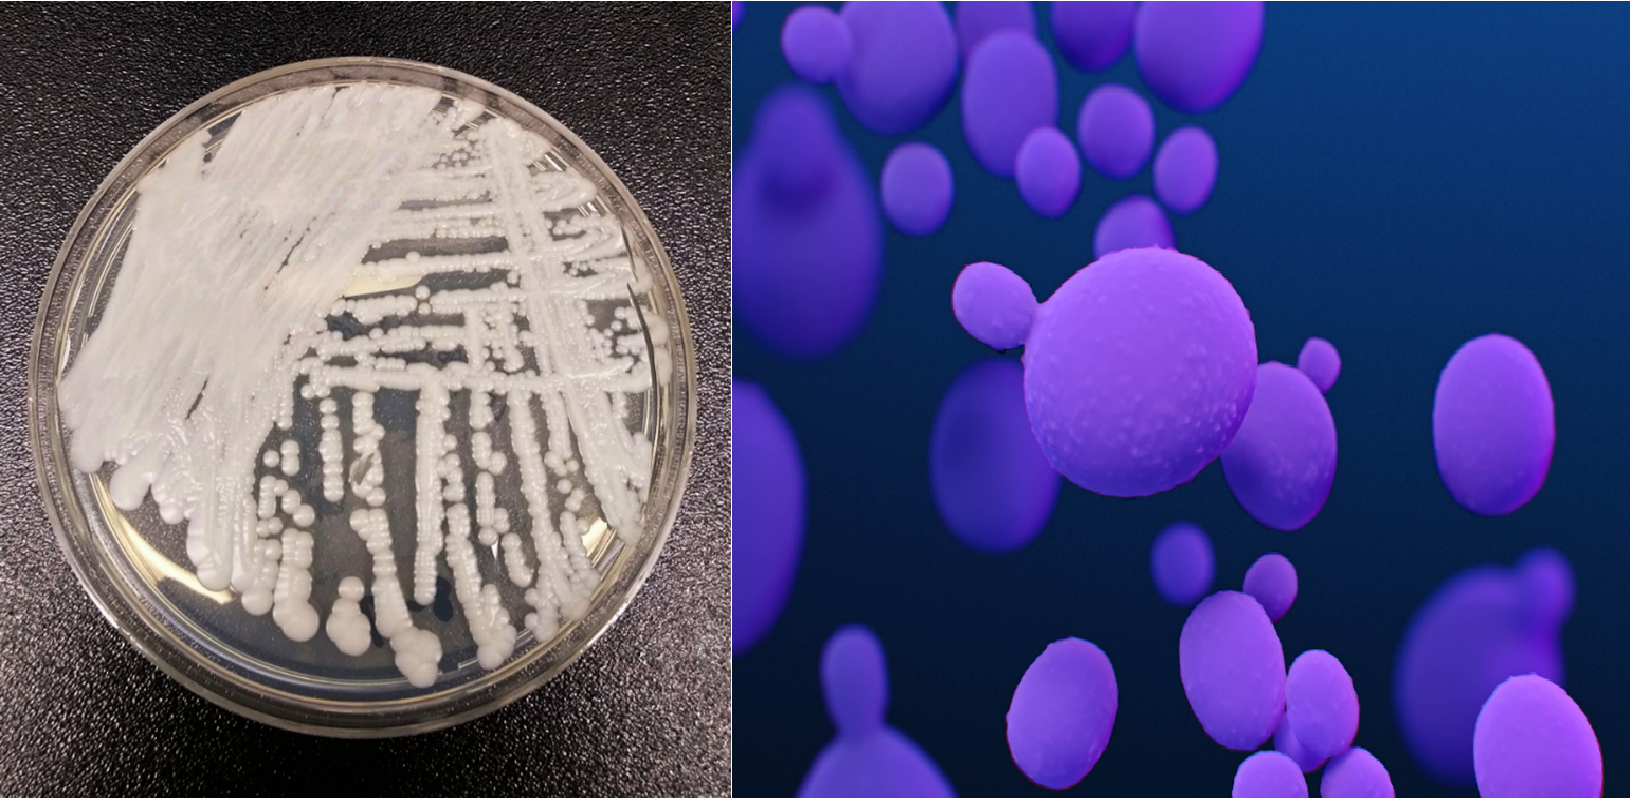

Antimicrobial Resistance Testing at DSHS

Antimicrobial Resistance: An Urgent Public Health Threat
Antimicrobial Resistance (AR) in a microbe develops when it is no longer affected by an antimicrobial substance that was developed to kill it. An antimicrobial-resistant microbe will continue growing and multiplying even in the presence of the antimicrobial. Several diseases that were once easily treated with antimicrobials are becoming more difficult to treat due to widespread resistance in bacteria and fungi. Antimicrobial resistance has become an urgent public health threat in the U.S. because infectious disease control relies on being able to treat and cure infectious diseases with medications that kill the infecting microbes.
Carbapenem Resistant Organisms
Carbapenems are a class of powerful antimicrobials used to treat severe infections caused by bacteria that are resistant to many other antimicrobials. Recently, several Gram-negative bacteria such as Klebsiella pneumoniae, Pseudomonas aeruginosa and Acinetobacter baumannii have developed resistance to these potent antimicrobials, leading to significant public health concerns about the spread of carbapenem resistance locally and globally. Together, these organisms are often referred to as Carbapenem Resistant Organisms, or CROs. K. pneumoniae, P. aeruginosa and A. baumannii are widespread in the environment; they are commonly found in soil and in the gastrointestinal tracts of people. These microbes usually only cause infections and illness in people who are immunocompromised, are in long-term health care facilities, or who have catheters or other invasive intubation of their bodies.
Carbapenem resistance may develop in populations of bacteria that are exposed to the antimicrobial or be acquired from genes bacteria “swap” with each other. The presence of carbapenem resistant bacteria in hospitals and long-term care facilities is of great concern as they can cause difficult-to-treat healthcare-associated infections (HAIs) in immunocompromised patients. Some carbapenem resistant bacteria produce enzymes called carbapenemases that break down carbapenems. Carbapenemase genes are often found on transferrable genetic material called plasmids, which allows the ability to produce these enzymes to be spread to other bacteria.

Medical illustrations of (L-R):Carbapenem resistant Enterobacterales (CRE) and Carbapenem-resistant Acinetobacter sp. Carbapenems are a class of potent antibiotics used to treat serious infections.
CRE Image Source: CDC/ Antibiotic Resistance Coordination and Strategy Unit. Medical Illustrator: Stephanie Rossow (2019). CRAB Image Source: CDC/ Antibiotic Resistance Coordination and Strategy Unit. Medical Illustrators: Dan Higgins; James Archer
CRO Testing at DSHS Austin Laboratory
The AR Laboratory characterizes the carbapenem resistance status of isolate specimens of several Gram-negative bacteria, including P. aeruginosa, A. baumannii, and several Enterobacterales genera. The laboratory also reports on the presence of carbapenemase genes in certain CRO specimens.
Refer to DSHS’ LTSM test menu for more details on CRO testing at Texas AR laboratory.
CRO specimen submission criteria, specimen collection and shipping guidance is found in the Submitting AR Specimens to DSHS section.
At left, Candida auris growth on a nutrient agar plate. At right, A digital medical illustration of Candida auris cells. In the foreground a C. auris cell is budding.
Image sources: Agar plate: CDC/ NCEZID; DFWED; MDB, Shawn Lockhart (2016); Digital image: CDC/ Antibiotic Resistance Coordination and Strategy Unit. Medical Illustrator: Stephanie Rossow (2019)
Candida auris
Candida auris is a multidrug-resistant species of fungus that can cause an infection called candidiasis. C. auris is a public health concern because of its multiple antimicrobial resistances, and it can be easily misidentified as other less dangerous Candida species. Despite being first isolated and described in Japan in 2009, C. auris spread quickly across the globe, causing severe infections, most commonly in immunocompromised patients. Healthy people usually do not get C. auris infections. But C. auris can colonize the skin of healthy people, who can be asymptomatic carriers. People at highest risk of developing a C. auris infection are usually patients who have been in a healthcare facility for a long time, who have a central venous catheter or other forms of invasive intubation in their body, or who have previously received antibiotics or antifungal medications.
Candida auris Testing at DSHS Austin Laboratory
The Texas AR Laboratory can accurately identify C. auris from clinical specimens (swabs) and cultured isolates. The Laboratory encourages specialized nursing facilities and other long-term care facilities in particular to submit clinical specimens and isolates for C. auris colonization and identification testing so we can rapidly assist in responding to the public health threat posed by this fungal organism.
C. auris specimen submission criteria, specimen collection and shipping guidance is found in the [Submitting AR Specimens to DSHS section.

Medical illustration of Neisseria gonorrhoeae.
Image Source: CDC/ Antibiotic Resistance Coordination and Strategy Unit. Alissa Eckert (2019)
Antimicrobial Resistant Neisseria gonorrhoeae
The bacterium that causes the sexually-transmitted infection gonorrhea, Neisseria gonorrhoeae commonly referred to as gonococcus, or GC, has developed resistance to almost every antimicrobial used to treat it. As a result, cephalosporins are the class of antimicrobials currently recommended for treatment of gonorrhea. CDC recommends using ceftriaxone, a type of cephalosporin antimicrobial for gonorrhea treatment. The emergence of cephalosporin-resistant N. gonorrhoeae would greatly affect providers’ ability to successfully treat gonorrhea in patients. Therefore, the monitoring of antimicrobial resistance in N. gonorrhoeae is a public health priority for Texas.
Neisseria gonorrhoeae Susceptibility Testing at DSHS Austin Laboratory
The AR Laboratory conducts antimicrobial susceptibility testing (AST) on GC specimens taken from patients with suspected gonorrhea treatment failure. Isolates are tested for sensitivity to azithromycin, cefixime, ciprofloxacin, and ceftriaxone—to assist in the care of patients with potentially drug-resistant gonorrhea. GC AST is a reflex test for all GC culture submissions and is intended for use with suspected cases of gonorrhea treatment failure. Refer to DSHS’ LTSM test menu for more details on the GC AST.
Suspected treatment-resistant N. gonorrhoeae specimen submission criteria, specimen collection and shipping guidance is found in the Submitting AR Specimens to DSHS.